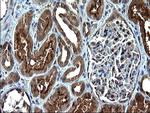
SCP2 Antibody in Immunohistochemistry (Paraffin) (IHC (P))

Search
OriGene
SCP2 Monoclonal Antibody (OTI1E4), TrueMAB™
{{$productOrderCtrl.translations['antibody.pdp.commerceCard.promotion.promotions']}}
{{$productOrderCtrl.translations['antibody.pdp.commerceCard.promotion.viewpromo']}}
{{$productOrderCtrl.translations['antibody.pdp.commerceCard.promotion.promocode']}}: {{promo.promoCode}} {{promo.promoTitle}} {{promo.promoDescription}}. {{$productOrderCtrl.translations['antibody.pdp.commerceCard.promotion.learnmore']}}
产品信息
TA507247
种属反应
宿主/亚型
分类
类型
克隆号
抗原
偶联物
形式
浓度
规格
纯化类型
保存液
内含物
保存条件
运输条件
靶标信息
This gene encodes two proteins: sterol carrier protein X (SCPx) and sterol carrier protein 2 (SCP2), as a result of transcription initiation from 2 independently regulated promoters. The transcript initiated from the proximal promoter encodes the longer SCPx protein, and the transcript initiated from the distal promoter encodes the shorter SCP2 protein, with the 2 proteins sharing a common C-terminus. Evidence suggests that the SCPx protein is a peroxisome-associated thiolase that is involved in the oxidation of branched chain fatty acids, while the SCP2 protein is thought to be an intracellular lipid transfer protein. This gene is highly expressed in organs involved in lipid metabolism, and may play a role in Zellweger syndrome, in which cells are deficient in peroxisomes and have impaired bile acid synthesis. Alternative splicing of this gene produces multiple transcript variants, some encoding different isoforms.
仅用于科研。不用于诊断过程。未经明确授权不得转售。
篇参考文献 (0)
生物信息学
蛋白别名: Acetyl-CoA C-myristoyltransferase; epididymis secretory sperm binding protein; Non-specific lipid-transfer protein; NSL-TP; Propanoyl-CoA C-acyltransferase; SCP-2; SCP-2/3-oxoacyl-CoA thiolase; SCP-2/thiolase; SCP-chi; SCP-X; SCPX; Sterol carrier protein 2; Sterol carrier protein X; straight-chain acyl-CoA oxidase; unnamed protein product
基因别名: NLTP; NSL-TP; SCOX; SCP-2; SCP-CHI; SCP-X; SCP2; SCPX
UniProt ID: (Human) P22307
Entrez Gene ID: (Human) 6342